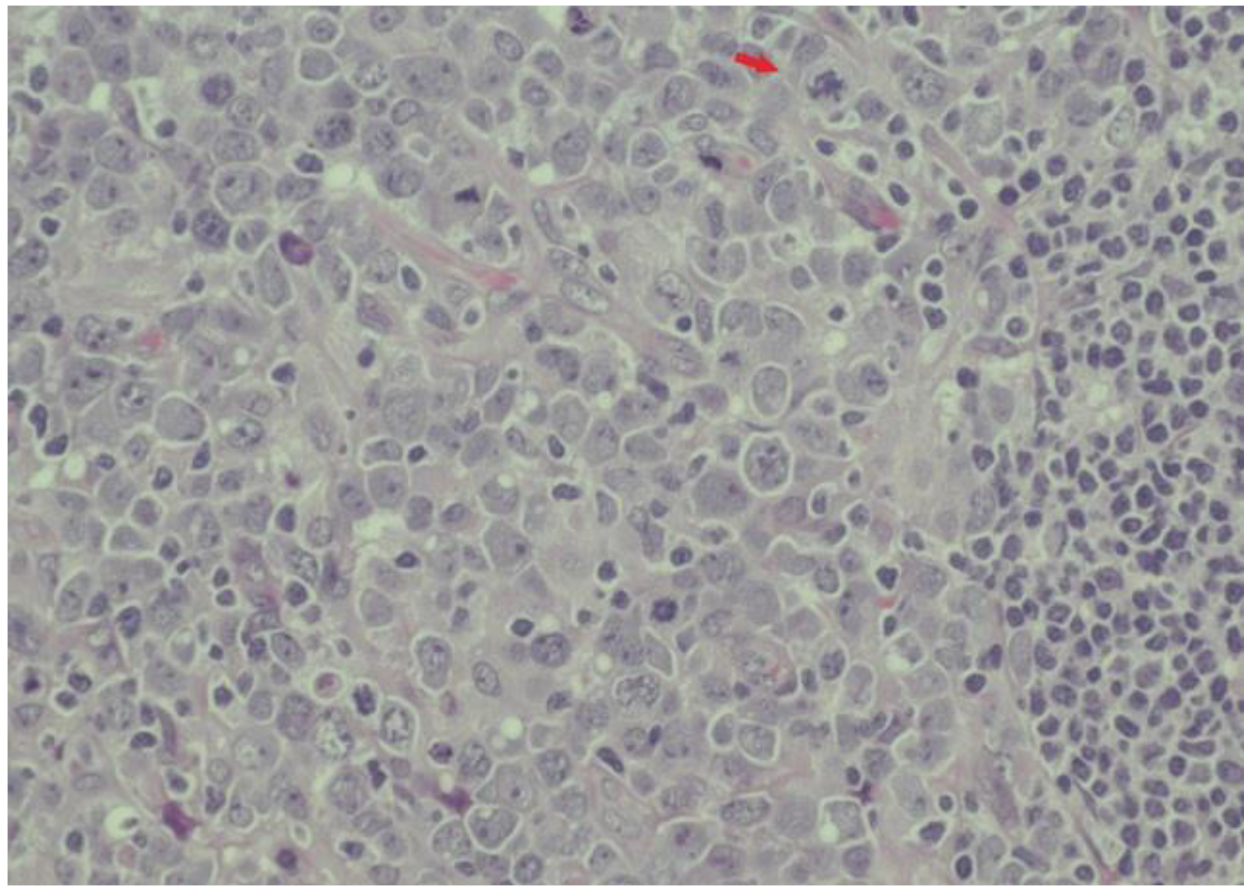

Non-Hodgkin Lymphoma Developed Shortly after mRNA COVID-19 Vaccination: Report of a Case and Review of the Literature
Abstract
:1. Introduction
2. Case Report
3. Revision of the Literature
Methods
4. Results of the Literature Revision
5. Discussion
Author Contributions
Funding
Institutional Review Board Statement
Informed Consent Statement
Data Availability Statement
Conflicts of Interest
References
- Hartsock, R.J. Postvaccinial lymphadenitis. Hyperplasia of lymphoid tissue that simulates malignant lymphomas. Cancer 1968, 21, 632–649. [Google Scholar] [CrossRef] [PubMed]
- Studdiford, J.; Lamb, K.; Horvath, K.; Altshuler, M.; Stonehouse, A. Development of unilateral cervical and supraclavicular lymphadenopathy after human papillomavirus vaccination. Pharmacotherapy 2008, 28, 1194–1197. [Google Scholar] [CrossRef] [PubMed]
- Centers for Disease Control and Prevention. Local Reactions, Systemic Reactions, Adverse Events, and Serious Adverse Events: Pfizer-BioNTech COVID-19 Vaccine. Available online: https://www.cdc.gov/vaccines/covid-19/info-by-product/pfizer/reactogenicity.html (accessed on 10 December 2022).
- Becker, A.S.; Perez-Johnston, R.; Chikarmane, S.A.; Chen, M.M.; El Homsi, M.; Feigin, K.N.; Gallagher, K.M.; Hanna, E.Y.; Hicks, M.; Ilica, A.T.; et al. Multidisciplinary recommendations regarding post-vaccine adenopathy and radiologic imaging: Radiology scientific expert panel. Radiology 2021, 300, E323–E327. [Google Scholar] [CrossRef] [PubMed]
- Garcia-Molina, F.; Cegarra-Navarro, M.F.; Javier Andrade-Gonzales, R.; Martinez-Diaz, F. Cytologic and histologic features of COVID-19 post-vaccination lymphadenopathy. Cytojournal 2021, 18, 34. [Google Scholar] [CrossRef] [PubMed]
- Mizutani, M.; Mitsui, H.; Amano, T.; Ogawa, Y.; Deguchi, N.; Shimada, S.; Miwa, A.; Kawamura, T.; Ogido, Y. Two cases of axillary lymphadenopathy diagnosed as diffuse large B-cell lymphoma developed shortly after BNT162b2 COVID-19 vaccination. J. Eur. Acad. Dermatol. Venereol. 2022, 36, e613–e615. [Google Scholar] [CrossRef]
- Zamfir, M.A.; Moraru, L.; Dobrea, C.; Scheau, A.E.; Iacob, S.; Moldovan, C.; Cristian Scheau, C.; Caruntu, C.; Caruntu, A. Hematologic Malignancies Diagnosed in the Context of the mRNA COVID-19 Vaccination Campaign: A Report of Two Cases. Medicina 2022, 58, 874. [Google Scholar] [CrossRef]
- Tang, W.R.; Hsu, C.W.; Lee, C.C.; Huang, W.L.; Lin, C.Y.; Hsu, Y.T.; Chang, C.; Tsai, M.T.; Hu, Y.N.; Hsu, C.H.; et al. A Case Report of Posttransplant Lymphoproliferative Disorder after AstraZeneca Coronavirus Disease 2019 Vaccine in a Heart Transplant Recipient. Transplant. Proc. 2022, 54, 1575–1578. [Google Scholar] [CrossRef]
- Kreher, M.A.; Ahn, J.; Werbel, T.; Motaparthi, K. Subcutaneous panniculitis-like T-cell lymphoma after COVID-19 vaccination. JAAD Case Rep. 2022, 28, 18–20. [Google Scholar] [CrossRef]
- Sekizawa, A.; Hashimoto, K.; Kobayashi, S.; Kozono, S.; Kobayashi, T.; Kawamura, Y.; Kimata, M.; Fujita, N.; Ono, Y.; Obuchi, Y.; et al. Rapid progression of marginal zone B-cell lymphoma after COVID-19 vaccination (BNT162b2): A case report. Front. Med. 2022, 9, 963393. [Google Scholar] [CrossRef]
- Revenga-Porcel, L.; Peñate, Y.; Granados-Pacheco, F. Anaplastic large cell lymphoma at the SARS-CoV2 vaccine injection site. J. Eur. Acad. Dermatol. Venereol. 2023, 37, e32–e34. [Google Scholar] [CrossRef]
- Mehta, N.; Sales, R.M.; Babagbemi, K.; Levy, A.D.; McGrath, A.L.; Drotman, M.; Dodelzon, K. Unilateral axillary lymphadenopathy in the setting of COVID-19 vaccine. Clin. Imaging 2021, 75, 12–15. [Google Scholar] [CrossRef]
- Lane, D.L.; Neelapu, S.S.; Xu, G.; Weaver, O. COVID-19 Vaccine-Related Axillary and Cervical Lymphadenopathy in Patients with Current or Prior Breast Cancer and Other Malignancies: Cross-Sectional Imaging Findings on MRI, CT, and PET-CT. Korean J. Radiol. 2021, 22, 1938–1945. [Google Scholar] [CrossRef] [PubMed]
- Washington, T.; Bryan, R.; Clemow, C. Adenopathy following COVID19 vaccination. Radiology 2021, 299, E280–E281. [Google Scholar] [CrossRef]
- Lehman, C.D.; D’Alessandro, H.A.; Mendoza, D.P.; Succi, M.D.; Kambadakone, A.; Lamb, L.R. Unilateral Lymphadenopathy after COVID-19 Vaccination: A Practical Management Plan for Radiologists Across Specialties. J. Am. Coll. Radiol. 2021, 18, 843–852. [Google Scholar] [CrossRef] [PubMed]
- Goldman, S.; Bron, D.; Tousseyn, T.; Vierasu, I.; Dewispelaere, L.; Heimann, P.; Cogan, E.; Goldman, M. Rapid Progression of Angioimmunoblastic T Cell Lymphoma Following BNT162b2 mRNA Vaccine Booster Shot: A Case Report. Front. Med. 2021, 8, 798095. [Google Scholar] [CrossRef] [PubMed]
- Suleman, A.; Bilbily, A.; Cheung, M.; Chodirker, L. Hypermetabolic lymphadenopathy on positron emission tomography scan following COVID-19 vaccination: A mimicker of disease progression in Hodgkin lymphoma. eJHaem 2021, 2, 678–679. [Google Scholar] [CrossRef]
- Arens, A.I.J.; Hebeda, K.M.; Hutchings, M.; Plattel, W.J.; Stevens, W.B.C. Axillary lymph nodes on PET in Hodgkin lymphoma after COVID-19 vaccination. eJHaem 2021, 2, 885–886. [Google Scholar] [CrossRef]
- Xu, G.; Lu, Y. COVID-19 mRNA Vaccination-Induced Lymphadenopathy Mimics Lymphoma Progression on FDG PET/CT. Clin. Nucl. Med. 2021, 46, 353–354. [Google Scholar] [CrossRef]
- Landete, E.; Gómez-Fernández, I.; González-Gascón-y-Marín, I.; Durán-Barquero, C.; Churruca, J.; Infante, M.S.; Muñoz-Novas, C.; Foncillas, M.Á.; Marín, K.; Ramos-de-Ascanio, V.; et al. Hypermetabolic abdominal and cervical lymph nodes mimicking Hodgkin lymphoma relapse on FDG PET/CT after adenovirus-vectored COVID-19 vaccine. Hum. Vaccines Immunother. 2021, 17, 5129–5132. [Google Scholar] [CrossRef]
- Sousa, L.G.; McGrail, D.J.; Li, K.; Marques-Piubelli, M.L.; Gonzalez, C.; Dai, H.; Ferri-Borgogno, S.; Godoy, M.; Burks, J.; Lin, S.Y.; et al. Spontaneous tumor regression following COVID-19 vaccination. J. Immunother. Cancer 2022, 10, e004371. [Google Scholar] [CrossRef]
- Gambichler, T.; Boms, S.; Hessam, S.; Tischoff, I.; Tannapfel, A.; Lüttringhaus, T.; Beckman, J.; Stranzenbach, R. Primary cutaneous anaplastic large-cell lymphoma with marked spontaneous regression of organ manifestation after SARS-CoV-2 vaccination. Br. J. Dermatol. 2021, 185, 1259–1262. [Google Scholar] [CrossRef]

| Case N. | Gender/Age (Year) (Reference) | Time from Vaccination to Onset of Lymphoproliferative Disorder | Histopathological Examination | Type of COVID-19 Vaccine | Site and Diameter of Lymphadenopathy | Treatment of Lymphoma |
|---|---|---|---|---|---|---|
| 1 | M/67 [6] | 1 day after 1 dose | DLBCL | BNT162b2 | Left axilla 6.0 cm | Chemotherapy plus rituximab |
| 2 | F/80 [6] | 2 days after 1 dose | DLBCL | BNT162b2 | Left axilla 4.1 cm | Chemotherapy plus rituximab |
| 3 | F/58 [7] | 7 days after 2 dose | DLBCL | BNT162b2 | Left cervical area 4 cm | Radical surgery plus radiotherapy |
| 4 | M/53 [7] | 3 days after 1 dose | Extranodal NK/T-cell lymphoma | BNT162b2 | Erosive lesions upper lip up to 5 mm | Chemotherapy plus radiotherapy |
| 5 | M/51 [8] | 7 days after 1 dose | EBV-positive DLBCL | ChAdox1 nCOV-19 | Mediastinal mass 5 cm | Rituximab |
| 6 | F/28 [9] | “A few days after 1 dose” | SPTCL | Ad26 viral-vector-based | Injection site, upper arm | Cyclosporine plus prednisone |
| 7 | F/80 [10] | 1 day after 1 dose | EMZL | BNT162b2 | Right temporal mass | No treatment |
| 8 | M/76 [11] | 10 days after the booster dose | PC-ALCL | mRNA-1273 * | Right arm upper-external surface 6 cm | No treatment |
Disclaimer/Publisher’s Note: The statements, opinions and data contained in all publications are solely those of the individual author(s) and contributor(s) and not of MDPI and/or the editor(s). MDPI and/or the editor(s) disclaim responsibility for any injury to people or property resulting from any ideas, methods, instructions or products referred to in the content. |
© 2023 by the authors. Licensee MDPI, Basel, Switzerland. This article is an open access article distributed under the terms and conditions of the Creative Commons Attribution (CC BY) license (https://creativecommons.org/licenses/by/4.0/).
Share and Cite
Cavanna, L.; Grassi, S.O.; Ruffini, L.; Michieletti, E.; Carella, E.; Palli, D.; Zangrandi, A.; Inzerilli, N.; Bernuzzi, P.; Di Nunzio, C.; et al. Non-Hodgkin Lymphoma Developed Shortly after mRNA COVID-19 Vaccination: Report of a Case and Review of the Literature. Medicina 2023, 59, 157. https://doi.org/10.3390/medicina59010157
Cavanna L, Grassi SO, Ruffini L, Michieletti E, Carella E, Palli D, Zangrandi A, Inzerilli N, Bernuzzi P, Di Nunzio C, et al. Non-Hodgkin Lymphoma Developed Shortly after mRNA COVID-19 Vaccination: Report of a Case and Review of the Literature. Medicina. 2023; 59(1):157. https://doi.org/10.3390/medicina59010157
Chicago/Turabian StyleCavanna, Luigi, Sergio Ottavio Grassi, Livia Ruffini, Emanuele Michieletti, Egidio Carella, Dante Palli, Adriano Zangrandi, Nicola Inzerilli, Patrizia Bernuzzi, Camilla Di Nunzio, and et al. 2023. "Non-Hodgkin Lymphoma Developed Shortly after mRNA COVID-19 Vaccination: Report of a Case and Review of the Literature" Medicina 59, no. 1: 157. https://doi.org/10.3390/medicina59010157
APA StyleCavanna, L., Grassi, S. O., Ruffini, L., Michieletti, E., Carella, E., Palli, D., Zangrandi, A., Inzerilli, N., Bernuzzi, P., Di Nunzio, C., & Citterio, C. (2023). Non-Hodgkin Lymphoma Developed Shortly after mRNA COVID-19 Vaccination: Report of a Case and Review of the Literature. Medicina, 59(1), 157. https://doi.org/10.3390/medicina59010157

